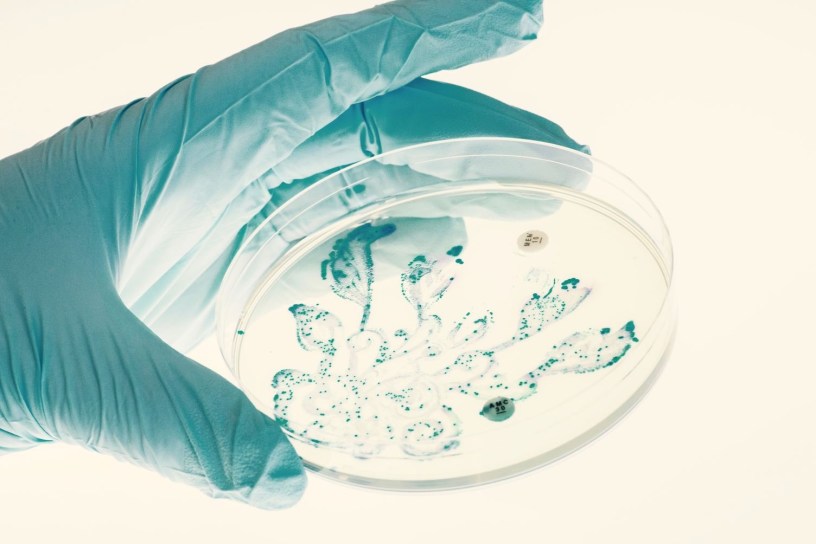

Bash the Bug has been shortlisted for an Online Community Award in the NIHR Let’s Get Digital Competition.
Voting closes tomorrow (Wednesday 2nd of August) – you can show your support by voting here!
Bash the Bug has been shortlisted for an Online Community Award in the NIHR Let’s Get Digital Competition.
Voting closes tomorrow (Wednesday 2nd of August) – you can show your support by voting here!